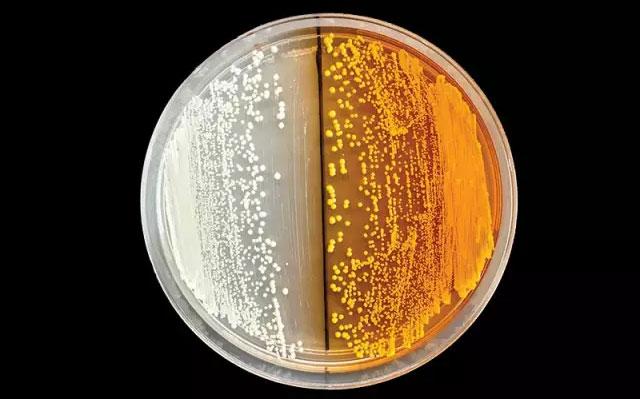

《科学》杂志:2015年10大年度科学发现

北京时间12月18日,《科学》杂志评选出的年度十大科学发现终于出炉。备受关注的CRISPR基因编辑技术“从过去数年陪跑,今年终于登上年度科学发现的桂冠,拔得头筹”。兹详细介绍如下。

1 强大的CRISPR技术
2007年,一家酸奶公司发现一种细菌拥有抵御病毒的特殊防御机制。2012年,细菌的这种机制就被科学家阐述清楚,2013年这一领域快速增长。它被视为分子生物学的一个奇迹,事实上,它并非仅对生物学家产生革命的影响,这个世界同样也会随之而改变。这就是基于CRISPR系统的基因编辑技术。
早在2012年和2013年,《科学》杂志就已将CRISPR纳入到年度10大科学发现的榜单中,不过它属于陪跑“角色”。随着近些年来一系列的重要科学发现,CRISPR基因编辑技术备受注目,其中最重要的两项研究是:修饰物种的基因,以减少其数量或减少其携带的疾病(如蚊子等),以及人类胚胎细胞的基因组编辑,它们的出现都给现有的科学秩序提出严重挑战。胚人类胚胎细胞基因修饰工作由中山大学学者完成,该研究亦成为12月份在华盛顿召开的国际人类基因编辑峰会(International Summiton Human Gene Editing)的一个重要导火索。
基因编辑技术其实并不很新鲜,胎细胞基因修饰工作由中山大学学者完成,该研究亦成为12月份在华盛顿召开的国际人类基因编辑峰会(International Summiton Human Gene Editing)的一个重要导火索。
基因编辑技术其实并不很新鲜,此前的技术有ZFN和TALENs。目前已经有几家公司利用基因编辑技术用于临床治疗,相比去前面两项技术,CRISPR基因编辑技术简单很多,以至于“每个分子生物实验室都在想做CRIPSR基因编辑技术”。非营利组织Addgene,目前已经发布了50000种质粒,这是一种环状的DNA,里面包含CRISPR系统中两种关键的部件:向导RNA(Guide RNA),能与特殊DNA片段结合;另外一个重要组分是DNA剪切酶,通常将其称为Cas9。CRISPR系统的最早发现者之一、加州伯克利分校的分子生物学家Jennifer Doudna表示,“它就像PCR技术,一个潜藏在工具箱里的工具”。CRISPR系统拥有如此强大的能力,以至于科学家很容易地创造出基因型完全不同的生命体。

2 矮行星之年
2015年,是矮行星之年。今年3月份,黎明号探测器(Dawn)进入谷神星(Ceres)轨道,谷神星是太阳系中最小的矮行星。7月份,新视野号(New Horizons)探测器与冥王星擦肩而过,它的主要目标是探测冥王星及其最大的卫星,以及位于柯伊柏带(Kuiper belt)的小行星群。

3 肯纳威克人的骨架
从一开始,人们就对所谓肯纳威克人(Kennewick Man)的遗骸争论不休。1996年,人类学家在华盛顿州哥伦比亚河肯纳威克海岸发现了它,它距今有8500年。人类学家讨论它与现在美洲土著居民的关系。但当地土著居民却认为这是他们祖先的遗骸,要求将其归还给他们,需厚葬之。2004年,美国政府开始资助研究者对这幅骨架进行研究。今年研究结果出来了,分子生物学家基因测序的结果是,肯纳威克人的DNA与华盛顿地区5个土著部落均有关,更重要的是,它从基因组层面证实了现在的美洲土著居民是15000年前从白令海峡迁徙过来的亚洲人的后代。这一证据有力地驳斥了那些认为美洲土著居民是后期迁徙过来亚洲人的后裔以及欧洲人后裔的观点。

4 心理学的再生
心理学目前正深陷数年前发表的上百篇顶级期刊论文的危机之中,在这些论文中充斥着太多的假阳性结果、少样本数量的实验以及弱相关性研究。事实上,早在2011年,研究者就关注了这种现象。2015年,心理学家开始对这些论文丑闻进行清算,今年8月份,270名心理学家重新审视了100项发在这一领域顶级期刊的研究,通过建立新的研究模型以及同行评议,他们得出了一个令人震惊的结论:仅有39%的研究的实验结果能够被验证。这让心理学家意识到未来这一领域发文章必须科学严谨,实验结果可重复,只有这样心理学才是一门严谨的科学。纵然此次心理学家拿自己开刀,但是它带来的契机是心理学的转变或再生。

5 新人种重现天日
2015年,人类又迎来一位新成员,一个由60名科学家组成的国际研究小组,在南非一处叫Rising Star洞穴中发现了一个新人种Homo naledi。该洞穴位于南非首都约翰内斯堡市西北处,研究者共发现了1500块化石,它们属于15个个体。
Homo naledi的分类学地位目前研究者并不清楚,它也许不属于现代人所处的属“Homo”。虽然新人种身高与现代人相近,而且通过其手臂的骨头鉴定,应该已开始直立行走,但是它们在其他特征上显得很原始,长而小的脑袋,弯曲的手指以及奇特的拇指,从而显示它们很有可能仍会在树上活跃,尤其是当遇到捕食者的时候。

6 深层地幔流研究渐热
40多年来,科学界一直争论热柱究竟是由地幔深处向上流动而成还是由浅一些的岩浆层构成的。通过全波型断层扫描技术发现,起源于地核向上流动的地幔柱已被检测出的确存在。科学家已检测到28股从地核涌来的热柱,热柱有800千米的厚度,这是理论预测值的三倍。也许我们需要重新思考,有关地核如何冷却降温的学说了。地球物理学家希望新技术最终能揭露地球内部的其他细节,例如海洋地壳俯冲的板块和深埋在地幔深处的“墓地”。

7 抗击埃博拉的疫苗
由世界卫生组织(WHO)领导的埃博拉疫苗终于研发出来了。尽管2014年,制药公司研发抗击埃博拉药物以及疫苗的热情空前高涨,但是药物研发的结果却并不让人满意。不过这一情况,在2015年得到了扭转。
由加拿大公共卫生部门(Public Health Agency of Canada)科学家研制的抗埃博拉药物,去年被制药公司默克(Merck)收购,该药物当时在猴子身上起了作用。收购之后,默克公司对该药物继续研究,在今年由世界卫生组织领导的临床研究中,该药物取得令人振奋的结果,7月31日,该研究发表在《柳叶刀》(TheLancet)杂志上,研究称这种疫苗的有效性达到75-100%。另一种由葛兰素史克公司研发的疫苗则难以证明其有效程度。纵然埃博拉已离我们远去,但是这种疫苗在下一次埃博拉疫情爆发时使用,也许能避免西非悲剧的重演。
8 酵母菌生产阿片类药物
一群美国生物学家将植物、细菌和啮齿动物基因混合导入酵母菌中,利用改造过的酵母菌成功合成蒂巴因(the baine),一种罂粟麻醉剂,它是诸多医用阿片类药物的前体。通过调整酵母途径,药物化学家可以合成更有效、成瘾性更小的麻醉剂和止痛剂。
不过,新技术暂时还不够完美:目前生产一剂止痛药要耗费20000升工程酵母。研究人员正在想办法提高工程酵母的效率和产出,优化它们的生化过程,以生产处安全、更有效的药物。

9 大脑中的淋巴管道
美国弗吉尼亚大学研究显示,大脑内也存在免疫系统的淋巴管道,这项新发现将颠覆几十年来教科书中“脑内没有淋巴管”的旧概念。它将有可能对从自闭症、阿尔茨海默综合症以及多发性硬化症等一些神经系统疾病的研究和治疗产生重要的影响。

10 贝尔无漏洞实验确认量子诡异特性
今年8月,荷兰代尔夫特技术大学的物理学家罗纳德·汉森(Ronald Hanson)领导的团队报道他们实现了第一例可以同时解决探测漏洞和通信漏洞的贝尔实验,证实相距1.3公里的成对电子之间存在“量子纠缠”,否定了爱因斯坦的隐变量理论。
这一实验结果并没有让物理学家们感到惊讶,但它所实现的距离1.3公里两个固态量子比特之间的量子纠缠制备,为未来实用化的全量子互联网奠定了重要技术支撑。
备注:本文所有图片来自Science杂志。
附件下载: